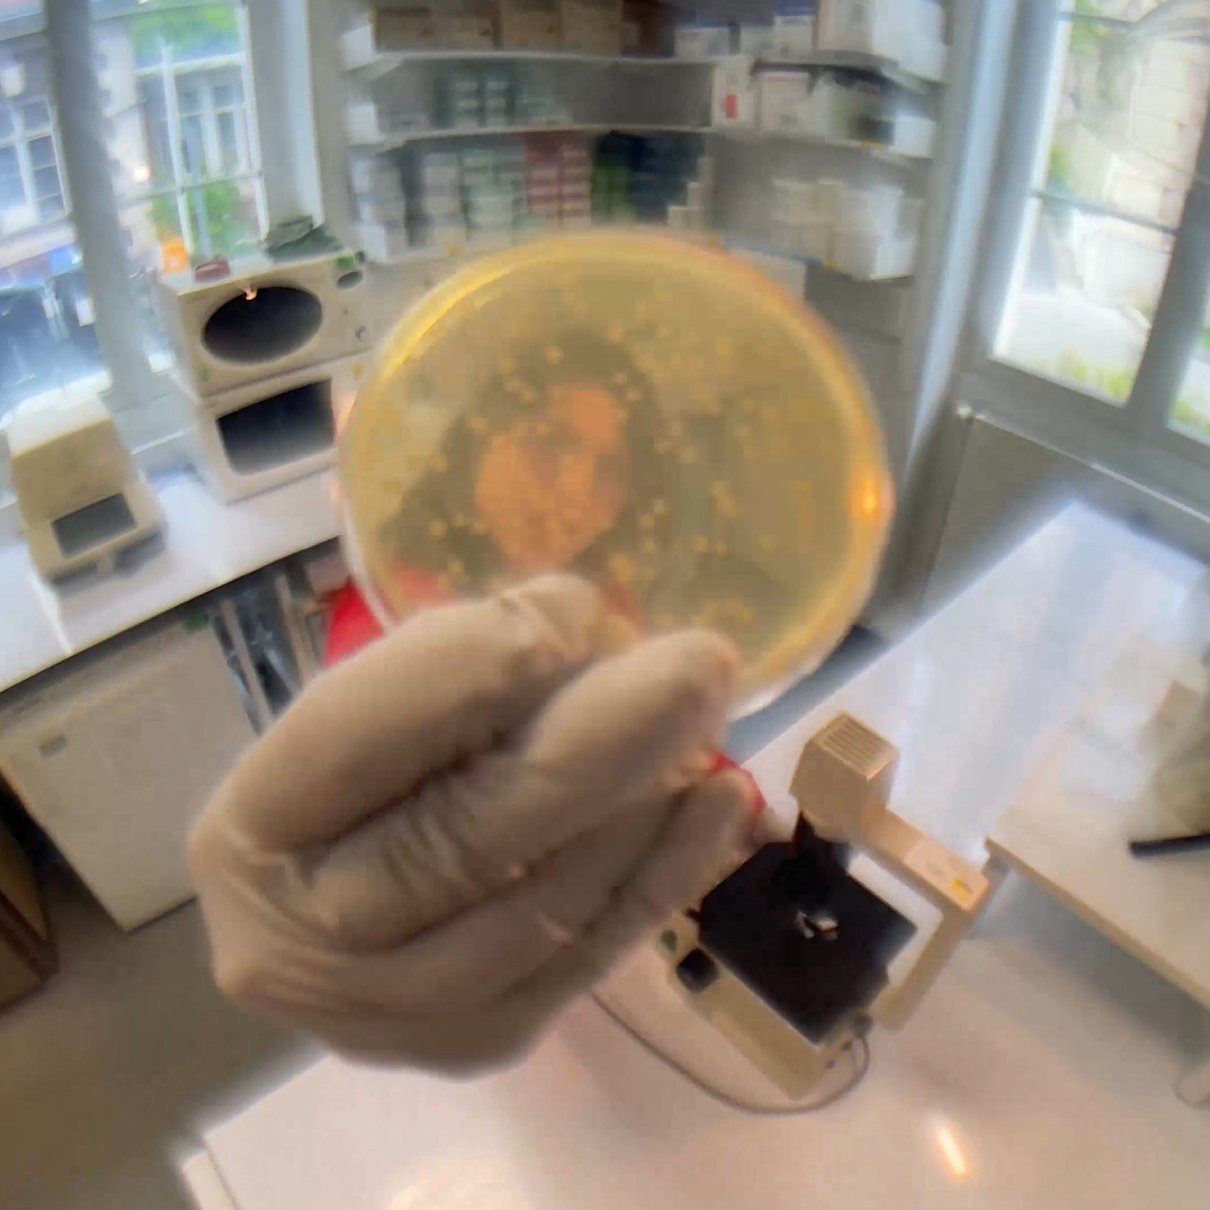

À l’occasion de la Journée internationale des droits des femmes du 8 mars 2026, Yaëlle Wormser, doctorante en microbiologie de l’Université Paris Cité à l’Institut Pasteur, aussi connue sous le nom d’artiste Lady Pipette dévoile « Mathilda », un clip musical engagé autour de l’effet Matilda. À la croisée de la science et de la création, ce projet met en lumière l’invisibilisation des femmes scientifiques, y compris dans l’histoire récente, et rend hommage à celles qui ont marqué la recherche.
Malgré des avancées notables, les inégalités de genre persistent dans le monde scientifique. À l’échelle mondiale, les femmes représentent environ 33 % des chercheur·se·s selon l’UNESCO. En France, la situation est tout aussi révélatrice : dans les disciplines STEM (science, technologie, ingénierie et mathématiques) moins d’un tiers des chercheur se·s et un quart des ingénieur·e·s sont des femmes, d’après un rapport du Sénat publié le 8 octobre 2025. Ce déséquilibre illustre le « plafond de verre » auquel elles se heurtent : alors qu’elles représentent 49 % des doctorant·e·s, leur présence diminue fortement dans les postes de responsabilité et les carrières scientifiques supérieures.
Dans le même temps, les initiatives visant à rendre visibles les contributions des femmes scientifiques se multiplient. En 2026, 72 noms de femmes scientifiques, dont 5 Pasteuriennes, seront inscrits sur la Tour Eiffel, un geste symbolique fort, venant corriger une absence et injustice historique. Jusqu’ici, 72 noms, exclusivement d’hommes scientifiques étaient inscrits depuis 1889. Ceci rappelle combien cette reconnaissance, bien que bienvenue, reste tardive.
L’effet Matilda : un biais systémique encore à l’œuvre
Hommage à cinq pionnières scientifiques
Lady Pipette rend hommage à cinq figures majeures de la science, dont les contributions ont souvent été sous-estimées ou méconnues :
Yaëlle explique le choix de ces cinq femmes tout en soulignant la difficulté de limiter son hommage à si peu de noms :
« J’aurais aimé pouvoir évoquer davantage de femmes scientifiques invisibilisées ou oubliées telles que Agnes Ullmann, Marie Pasteur, Lise Meitner, Élie Metchnikoff et tant d’autres, dont le parcours illustre aussi les conséquences de l’effet Matilda. Mais elles sont si nombreuses que le choix a été difficile ! Cette chanson est une invitation à découvrir toutes les femmes qui ont contribué à notre histoire et aux avancées majeures en science. »
Partagez le message de Mathilda
Mathilda est plus qu’une chanson : c’est un appel à reconnaître et célébrer les femmes dans la science. La vidéo, produite par la Direction de l’enseignement de l’Institut Pasteur est accessible sur toutes les plateformes d’écoute, ainsi que sur les comptes LinkedIn et YouTube Pasteur Education et le compte Instagram et TikTok de Lady Pipette.
N’hésitez pas à la regarder, à la partager et à diffuser ce message pour inspirer et encourager la prochaine génération de scientifiques. Chaque partage contribue à rendre visibles celles et ceux qui construisent l’histoire de la recherche.
En savoir plus sur l’effet Matilda
Découvrez The Matilda Project, une initiative qui met en lumière les contributions souvent invisibilisées des femmes scientifiques : Découvrir le projet (en anglais)
Diversité, Équité et Inclusion à l’Institut Pasteur
L’Institut Pasteur s’engage à promouvoir un environnement inclusif, équitable et respectueux, où chaque talent peut contribuer pleinement à l’avancée des sciences. Sa Direction DEI développe des initiatives concrètes et transversales à toutes les structures de l’Institut pour lutter contre les discriminations, valoriser la diversité sous toutes ses formes et renforcer l’égalité des genres, notamment via son Plan d’égalité des genres (GEP, 2022), sensibilisation et formation, groupes et réseaux. En 2025, l’Institut a obtenu un score de 99 % à l’index français de l’égalité professionnelle femmes-hommes et compte 40,7 % de femmes parmi ses instances dirigeantes, témoignant de son engagement durable pour une science plus inclusive.